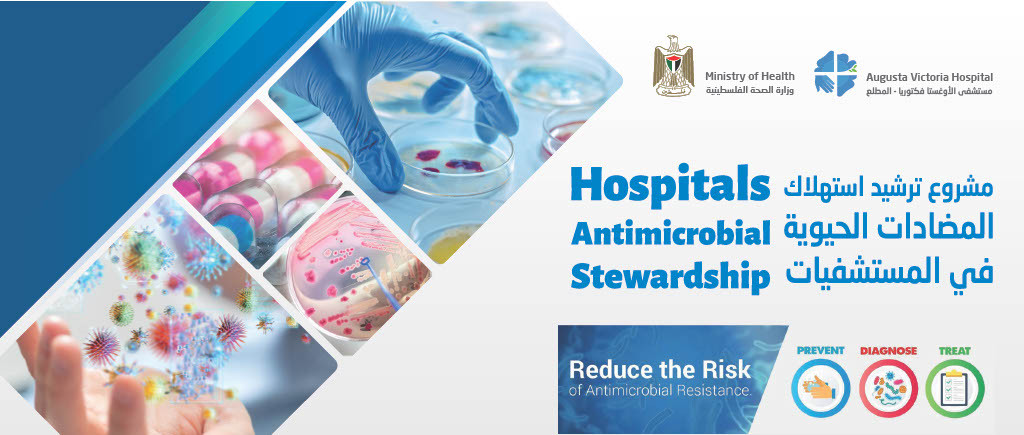
Anti-Microbial Stewardship Initiative

Anti-Microbial Stewardship Initiative
In 2016, Augusta Victoria Hospital participated in the East Jerusalem Hospitals Network Conference where the importance of national cooperation to reduce the spread of infection in the Palestinian health sector, including the East Jerusalem Hospitals Network, was emphasized.
The conference highlighted the need for standardizing diagnostic methods in laboratories and improving infection prevention methods in hospitals. Additionally, the conference stressed the importance of rationalizing antibiotic consumption to prevent the development and spread of antibiotic-resistant germs. In response to this, the infectious diseases department at the hospital worked to establish a system for monitoring and rationalizing antibiotic dispensation and improving infection prevention methods.
Additionally, the hospital built a microbiology laboratory to meet scientific and technical standards and provided continuing education and training for healthcare providers. The hospital also played a leading role in the Antibiotic Consumption Rationalization Project (AMSI) in partnership with the Palestinian Ministry of Health, which included approximately 30 hospitals and covered 70-80% of the Palestinian population receiving healthcare.
Through this project, medical staff were trained, a unified national protocol for the treatment of infectious diseases was established, and a computerized electronic system was built to collect data on antibiotic-resistant bacteria, antibiotic dispensation, and infection rates. AVH took a proactive approach in addressing the critical issue of antibiotic-resistant germs in the Palestinian health system.
